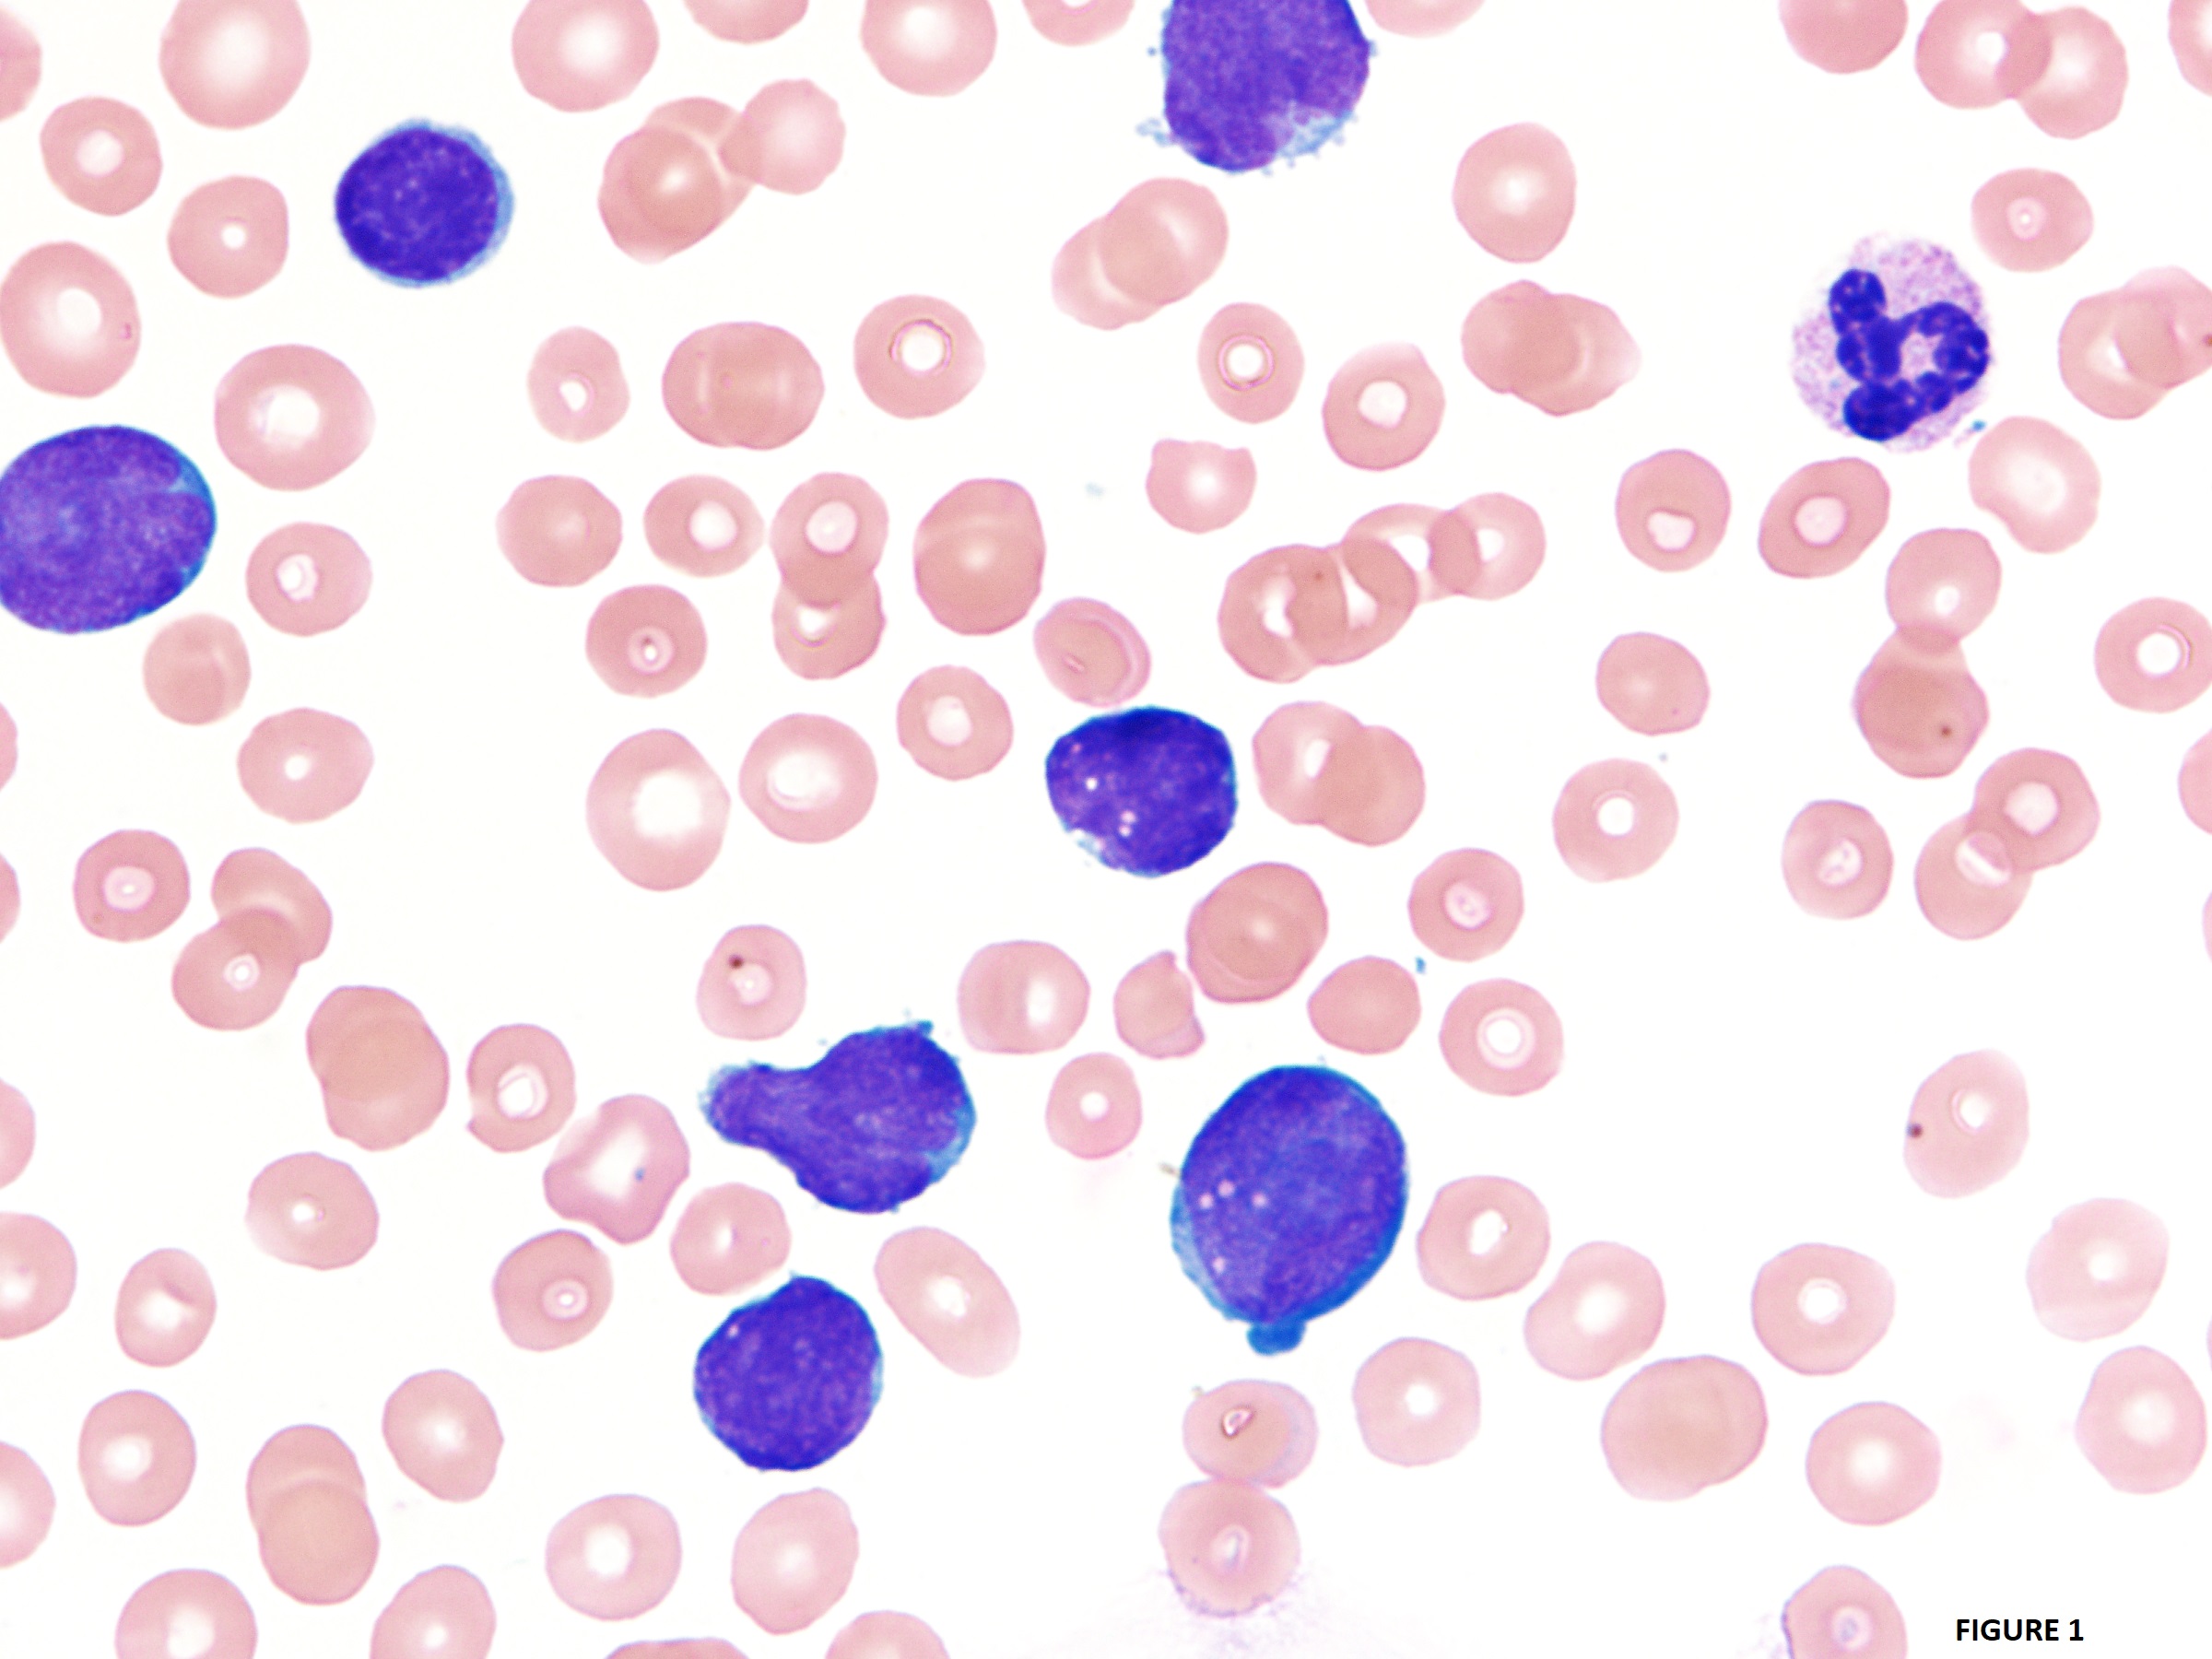

Case History
A 64-year old woman with no medical history presents with leukocytosis (Fig 1). Flow shows blasts with this phenotype: CD19+, CD10+, CD45lo, CD34+, CD20-/lo, nTdT+, cMPO-. FISH study shows 93.5% of the cells have the t(9;22)(q34;q11.2) resulting in BCR/ABL1 gene fusion.
What is the diagnosis?
- Chronic Myeloid Leukemia, BCR-ABL1-positive, in blast phase
- T-Acute lymphoblastic leukemia with t(9;22) (q34.1;q11.2); BCR-ABL1
- B-Acute lymphoblastic leukemia with t(9;22) (q34.1;q11.2); BCR-ABL1.
- Mixed phenotype acute leukemia with t(9;22) (q34.1;q11.2); BCR-ABL1
Answer: C. B-Acute lymphoblastic leukemia with t(9;22) (q34.1;q11.2); BCR-ABL1.
Discussion:
B-lymphoblastic leukaemia/lymphoma (B-ALL/LBL) with t(9;22)(q34.1;q11.2) is a neoplasm of lymphoblasts committed to the B-cell lineage in which the blasts harbor a translocation between BCR on chromosome 22 and the ABL1 oncogene on chromosome 9. Although Chronic Myeloid Leukemia (CML), BCR-ABL1-positive, in blast phase may present with a B-lymphoblastic leukemia phenotype, this patient has no medical history to indicate prior CML. Also, in most cases of blast phase of CML, the blast lineage is myeloid.
Source: Swerdlow, S. H. (Ed.). (2017). WHO classification of tumours of haematopoietic and lymphoid tissues. International Agency for Research on Cancer.
Case contributed by: Diana Morlote, M.D., Assistant Professor, Genomics Diagnostics & Bioinformatics